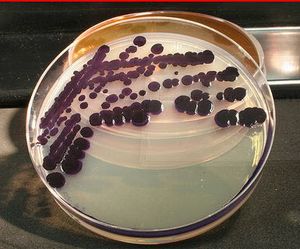

Research

Consider the set of ordered pairs [m]x[n] and the equation x+y=z. A rainbow solution is a subset of [m]x[n] of three ordered pairs that satisfy the equation. If we assign each ordered pair a color, what is the least number of colors we need to use to guarantee that there exists a rainbow solution? We call this number the anti-Schur number of x+y=z in [m]x[n]. More Info ->

Look at the picture above. The top pair of sidewalks look parallel, right? Now look at the bottom pair. Those sidewalks are clearly not parallel, but these are the same sidewalks as in the first picture with the right and left sidewalks switched. People also tend to misperceive the orientation of the sidewalks. In order to understand this effect, we directly measured the accuracy of perception when viewing multiple pictures. More Info ->
Many species of amphibians have been threatened by the fungus Batrachochytrium dendrobatidis (Bd), which causes the infectious disease chytridiomycosis (Chytrid). The bacteria Janthinobacterium lividum (J. liv), which naturally lives on the epidermis of amphibians, inhibits the growth of Bd and may help amphibians survive. In this study, we surveyed Wisconsin amphibians to determine the prevalence of J.liv. More Info ->